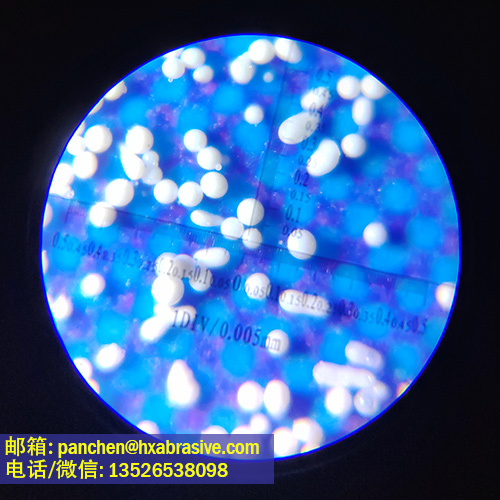
紫铜喷砂处理用陶瓷砂B170

紫铜喷砂处理用陶瓷砂B170
【产品名称】:陶瓷丸B170
【别称】:锆砂B170, 陶瓷珠,硅酸锆砂B170,陶瓷砂B170,陶瓷喷丸,锆铝复合丸,氧化锆喷丸,硅酸锆磨料,硅酸锆陶瓷砂,陶瓷喷丸磨料
【英文名称】:Ceramic Beads, Ceramic sand B170, Zircon Beads, Zriconium silicate beads B170, ceramic microbeads, ceramic microsphere, ceramic shot blasting media
紫铜喷砂处理用陶瓷砂B170颗粒大小为45-50um。它具有良好的耐磨性能,喷丸循环次数多。杂质少,有利于保持喷砂金属对象的表面清洁度。颗粒为球形,无棱角,喷砂效果更柔和光亮。它广泛应用于航空部件、不锈钢板、结构件、不锈钢厨具、医疗器械、手机/笔记本电脑外壳、汽车底盘/发动机、运动器材等行业的喷砂和表面处理。


紫铜喷砂处理用陶瓷砂B170(Ceramic sand)产品特点:
1. 强度高,耐磨。陶瓷丸主要成分为氧化锆,晶体尺寸小,耐磨性高。
2. 陶瓷砂硬度高,维氏硬度(显微硬度)达700HV,洛氏硬度达600HRC。其密度和比重也远高于玻璃珠。
3. 无粉尘、高耐磨性、高强度的特性使得陶瓷丸在喷砂过程中不易破碎,不易产生粉尘。
4. 喷砂效果:表面光洁度高。使用陶瓷丸喷砂可达到光滑缎面般的亮度。同规格陶瓷丸比玻璃珠喷砂成本降低60-70%。
5. 适用于各种金属和非金属,例如钛合金、镁合金、铝合金、不锈钢、碳钢、黄铜及合金、亚克力、塑料等材质。陶瓷丸不会与金属发生反应或氧化,且无金属残留,不会影响工件颜色。
6. 适用于干湿喷砂。陶瓷丸表面非常光滑,对喷砂设备的磨损很小。
7. 陶瓷丸喷砂效率高,使用寿命长,其循环使用次数可达玻璃珠的25倍。
8. 圆度高,球体间粘附异形球、雪人球的比例低。
紫铜喷砂处理用陶瓷砂B170(Ceramic sand)化学成分:
成分 | 标准值 | 检测值 |
ZrO2+Y2O3 | 60-70 | 65.13 |
SiO2 | 28-33 | 28.65 |
Al2O3 | Max.10 | 6.80 |
Fe2O3 | Max.0.06 | 0.02 |
TiO2 | Max.0.20 | 0.15 |
紫铜喷砂处理用陶瓷砂B170(Ceramic sand)物理指标:
项目 | 标准值 | 典型值 |
颗粒大小分布Particle Size | +50#(0.300mm) <10% 60-80#(0.180-0.250mm): 85-100% -80#(0.180mm)<10% | 4.6% 91.9% 3.5% |
比重Specific Gravity | 3.6-3.95 g/cm3 | 3.87 g/cm3 |
堆积密度Bulk Density | 2.10 g/cm3以上 | 2.24 g/cm3 |
维氏硬度Vickers Hardness | 700 HV以上 | 715 HV |
陶瓷砂型号列表:
型号 | 颗粒范围 | 直径分布 | 占比 |
B20 | 0.600-0.850 mm | >0.85mm | <5% |
0.6-0.85 mm | >90% | ||
<0.6 mm | <5% | ||
B30 | 0.425-0.600 mm | >0.6 mm | <5% |
0.425-0.60 mm | >90% | ||
<0.425 mm | <5% | ||
B40 | 0.250-0.425 mm | 0.425-0.500 mm | <5% |
0.250-0.425 mm | >90% | ||
<0.250 mm | <5% | ||
B60 | 0.125-0.250 mm | 0.250-0.300 mm | <5% |
0.125-0.250 mm | >90% | ||
<0.125 mm | <5% | ||
CB60 | 0.125-0.250 mm | 0.250-0.300 mm | <5% |
0.180-0.250 mm | 40-55% | ||
0.125-0.180 mm | 35-55% | ||
0.106-0.125 mm | <8% | ||
<0.106 mm | <5% | ||
CB60+ | 0.125-0.250 mm | 0.250-0.300 mm | <5% |
0.180-0.250 mm | 65-75% | ||
0.125-0.180 mm | 25-35% | ||
0.106-0.125 mm | <5% | ||
<0.106 mm | <2% | ||
B80 | 0.180-0.250 mm | 0.250-0.300 mm | <10% |
0.180-0.250 mm | 85-100% | ||
0.125-0.180 mm | <10% | ||
B100 | 0.125-0.180 mm | >0.180 mm | <10% |
0.125-0.180 mm | >80% | ||
<0.125 mm | <10% | ||
B120 | 0.063-0.150 mm | 0.150-0.212 mm | <3% |
0.125-0.150 mm | 35-45% | ||
0.063-0.125 mm | 55-65% | ||
<0.063mm | <5% | ||
NB120 | 0.063-0.125 mm | >0.212 mm | <3% |
0.125-0.212 mm | <10% | ||
0.063-0.125 mm | >80% | ||
<0.063 mm | <10% | ||
FB120 | 0.125-0.150 mm | >0.150 mm | <5% |
0.125-0.150 mm | >90% | ||
<0.090 mm | <5% | ||
B125 | 0-0.125 mm | >0.125 mm | <5% |
B150 | 0.063-0.150 mm | >0.150 mm | <5% |
<0.063 mm | <5% | ||
B170 | 0.045-0.150 mm | >0.150 mm | <5% |
0.045-0.150 mm | >90% | ||
<0.0.045 mm | <5% | ||
B170+ | 0.090-0.106 mm | >0.106 mm | <5% |
0.090-0.106 mm | 40-65% | ||
0.063-0.090 mm | 20-50% | ||
<0.063 mm | <10% | ||
BZ170 | 0.045-0.090 mm | >0.090 mm | <5% |
0.063-0.090 mm | 70-85% | ||
0.045-0.063 mm | 10-30% | ||
<0.045 mm | <7% | ||
BY170 | 0.045-0.090 mm | >0.090 mm | <5% |
0.045-0.090 mm | >85% | ||
<0.045 mm | <10% | ||
WB170 | 0-0.090 mm | >0.090 mm | <5% |
B205 | 0-0.063 mm | >0.063 mm | <5% |
B400 | 0.030-0.063 mm | >0.063 mm | <5% |
<0.053 mm | <30% | ||
B505 | 0.010-0.030 mm | >0.053 mm | <5% |
*特殊型号可接受定制.
产品用途:
1. 医疗领域:用于不锈钢手术器械、钛合金人体植入器械等表面处理,如去毛刺。
2. 高铁领域:可用于高铁铝合金零件表面喷砂处理,提升金属质感,形成光滑的缎面效果。用于高铁的研磨和精加工。
3. 汽车领域:陶瓷丸可用于汽车发动机铸件表面清理、去毛刺;用于清理汽车底板焊缝及焊点,为后续喷涂做准备;用于汽车弹簧喷丸强化,提高疲劳寿命;用于铝合金汽车轮毂的美化喷砂,消除应力,提高抗冲击性能。
4. 模具及机械加工:用于轮胎模具、注塑模具、冲压模具等不锈钢模具、铜模具、铝合金模具的喷砂处理,提升表面光洁度;清理机加工件的飞边、毛刺。
5. 电子设备领域:陶瓷丸用于铝合金或不锈钢材质的手机、平板电脑、手表等外壳的喷砂处理,可根据需要调节表面粗糙度和光泽度,并具有防指纹的特性。
6. 厨具行业:用于高品质不锈钢炊具、锅底、汤勺等产品的喷砂处理,赋予产品细腻的金属质感和一定的抗菌能力。
7. 玻璃制品行业:用于玻璃的雾化处理,替代氢氟酸化学蚀刻工艺,防止污染。
8. 航空零件喷丸强化:用于提高碳钢、钛合金、铝合金等航空机械零件的抗疲劳性能,消除表面应力。此外,还可用于飞机机翼、航空发动机涡轮叶片、涡轮盘、齿轮、起落架等表面强化。




产品包装: